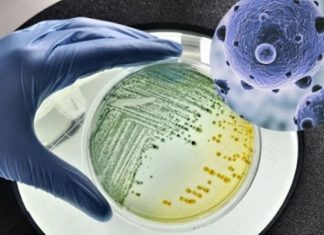
Dirty clogged showerhead breeds diseases, 2 simple ways to clean it sparkling like new

Tag: clean
The amazing benefits of using vinegar on meat that many people are unaware of
Adding vinegar to meat has great benefits, enhancing its flavor and making it more delicious.
What to do before using a new cutting board?
If you don't clean and treat it properly, a newly purchased wooden cutting board can easily become damp, moldy, and cracked, posing potential hygiene risks.
How to wash vegetables to remove all pesticides, preservatives, and have a worry-free meal
Knowing a few tips when washing vegetables can help you eliminate pesticides and preservatives that are commonly found on produce.
The amazing benefits of using ginger with baking soda to solve various household problems
It's amazing how ginger and baking soda can be so versatile when combined together!
There’s a small ‘agency’ in the rice cooker, save half of the electricity bill
Cleaning this part of the rice cooker will help the rice cook faster and save electricity.
Dirty clogged showerhead breeds diseases, 2 simple ways to clean it sparkling like new
Many people pay attention to cleaning their homes but often forget about the long-used showerhead that needs regular cleaning and scrubbing.
Expert reveals the culprit behind the unpleasant odor of refrigerators: It lies in a...
While refrigerators are a common electrical appliance in many households, not everyone is familiar with this component.
Best Practices for Safely Cleaning Front Load Washing Machines.
Regularly cleaning your washing machine is essential for maintaining a healthy environment. Neglecting this task can pose potential health risks. Below, we provide you with the safest and most effective way to clean your front-loading washing machine.
Ideal Temperature Setting for Refrigerator to Save Money Every Month
The refrigerator is one of the most energy-consuming appliances in the house. Luckily, there are a few handy tips that can help you cut costs when using it.
Effective Solution for Long-lasting Dirty and Smelly Dishwashing Sink
Dirty dishes in the sink are a common issue that many households have to deal with. However, not everyone knows how to address this problem.